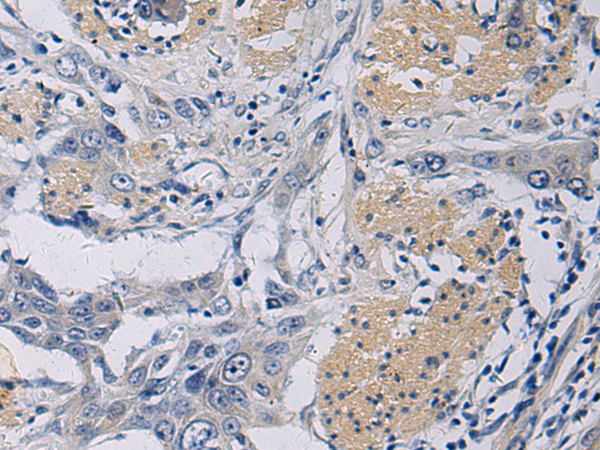

-
分类: 科研抗体货号: P13298别名: PAST; PAST1; H-PAST; HPAST1应用: WB反应种属: Human, Mouse, Rat
-
分类: 科研抗体货号: P13309别名: ETR3; ETR-3; NAPOR; CELF-2; CUGBP2; BRUNOL3; CUG-BP2应用: IHC反应种属: Human, Mouse, Rat
-
分类: 科研抗体货号: P13315别名: EMR3应用: WB,IHC反应种属: Human
-
分类: 科研抗体货号: P13297别名: SWS1应用: WB,IHC反应种属: Human, Mouse, Rat
-
分类: 科研抗体货号: P13308别名: GE; NE; HLE; HNE; ELA2; SCN1; PMN-E应用: IHC反应种属: Human
-
分类: 科研抗体货号: P13313别名: ELYS; MST108; TMBS62; MSTP108应用: IHC反应种属: Human, Mouse
-
分类: 科研抗体货号: P13326别名: 4.1G; 4.1-G应用: IHC反应种属: Human, Mouse
-
分类: 科研抗体货号: P13307别名: EKLF; EKLF/KLF1应用: IHC反应种属: Human
-
分类: 科研抗体货号: P13312别名: AN; AN2; hELP4; PAXNEB; PAX6NEB; C11orf19; dJ68P15A.1应用: IHC反应种属: Human
-
分类: 科研抗体货号: P13324别名: RTS; TYMSAS应用: IHC反应种属: Human

鄂公网安备42018502007531号
鄂公网安备42018502007531号

